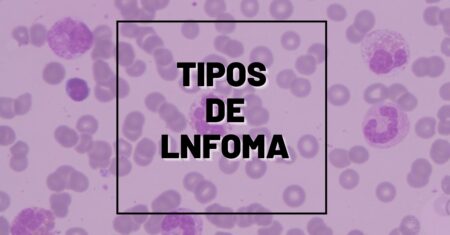
Quais são os Tipos de Linfoma: Hodgkin e Não Hodgkin – Sintomas, Diagnóstico Laboratorial e Tratamento

Introdução à Hematologia Básica: Guia Definitivo para Aprender Hematologia do Zero
A hematologia é uma das áreas mais importantes das análises clínicas e da medicina laboratorial. Presente diariamente em hospitais, laboratórios, bancos de sangue e centros de pesquisa, ela desempenha um papel fundamental no diagnóstico, monitoramento e tratamento de diversas doenças. Se você está iniciando seus estudos em Biomedicina, Farmácia, Medicina, Enfermagem ou Análises Clínicas, é […]
Quais são os Tipos de Linfoma: Hodgkin e Não Hodgkin – Sintomas, Diagnóstico Laboratorial e Tratamento
Quais são so tipos de linfoma: Hodgkin e não Hodgkin. Os linfomas são neoplasias malignas que se originam nas células do sistema linfático, principalmente nos linfócitos. O sistema linfático é uma parte essencial do sistema imunológico e inclui linfonodos (gânglios), baço, timo, medula óssea e vasos linfáticos. Quando ocorre uma transformação maligna nessas células, elas […]

Como diferenciar Leucemia de Linfoma no hemograma, sintomas e tratamento
Como diferenciar Leucemia de Linfoma. As doenças hematológicas malignas estão entre as condições mais importantes diagnosticadas em laboratórios clínicos. Entre elas, leucemias e linfomas são frequentemente confundidos por estudantes e até por profissionais da saúde em início de carreira, pois ambas pertencem ao grupo das neoplasias hematológicas e podem apresentar sinais laboratoriais e clínicos semelhantes. […]

Hemoglobina Glicada (HbA1c): para que serve e como reduzir de forma segura
A hemoglobina glicada (HbA1c) parar que serve e como reduzir de forma segura é um dos exames laboratoriais mais importantes para avaliar o controle da glicose no sangue ao longo do tempo. Muito utilizada no diagnóstico e no acompanhamento do diabetes mellitus, ela fornece uma visão ampla do comportamento glicêmico dos últimos meses. Se você […]

Eritropoiese: A Produção de Hemácias de Forma Fácil e Completa
Eritropoiese a produção de hemácias. A eritropoiese é o processo pelo qual o corpo humano produz hemácias (também chamadas de eritrócitos ou glóbulos vermelhos). Hemácias são as células sanguíneas responsáveis pelo transporte de oxigênio dos pulmões para os tecidos e de dióxido de carbono dos tecidos de volta para os pulmões. Esse processo é essencial […]

Como Diferenciar Células Hematológicas em 3 Passos: Guia Completo para Profissionais de Análises Clínicas
Como Diferenciar células hematológicas é uma das habilidades mais importantes dentro da rotina do laboratório clínico. É também um dos maiores desafios para estudantes, biomédicos, farmacêuticos, biólogos e profissionais das análises clínicas que desejam alcançar segurança diagnóstica, precisão morfológica e capacidade real de interpretar achados no hemograma. A morfologia hematológica vai muito além de simplesmente […]

Quais doenças o hemograma pode detectar?
Quais doenças o hemograma pode detectar. O hemograma é um dos exames laboratoriais mais solicitados na prática clínica e nas análises clínicas. Ele fornece informações valiosas sobre o estado geral da saúde, ajudando a identificar doenças hematológicas, infecções, processos inflamatórios e até deficiências nutricionais. Por meio da análise dos elementos figurados do sangue — glóbulos […]

Cascata de Coagulação: Entenda de forma simples o Mecanismo que Impede Hemorragia
Cascata de Coagulação entenda de forma simples o mecanismo que impede a hemorragia, a coagulação sanguínea é um mecanismo vital para a sobrevivência. Sempre que ocorre uma lesão vascular, o corpo precisa agir rapidamente para evitar perdas excessivas de sangue e restaurar a integridade do vaso. Esse processo é conhecido como hemostasia, e a cascata […]